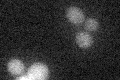
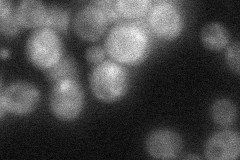
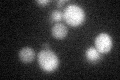
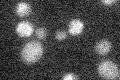

View description
Protein required for oxidation of specific cysteine residues of the transcription factor Yap1p, resulting in the nuclear localization of Yap1p in response to stress
Localization:
Intensity:
Fold change:
Significance:
-
C’ GFP library in SD
below threshold16.35 -
N' NOP1pr-GFP in SD

cytosol76.3807 -
N' TEF2pr-mCherry in SD

cytosol109.999 -
N' NATIVEpr-GFP in SD
cytosol,punctate33.5654 -
N' TEF2pr-VC and Cyto-VN in SD

cytosol49.7681 -
C’ GFP library in SD+DTT
cytosol17.581.07No -
C’ GFP library in SD+H2O2

cytosol19.491.19No -
C’ GFP library in Starvation Media
cytosol15.440.94No -
C’ GFP library on the background of Pup2-DaMP

below threshold -
C’ GFP library on the background of CCT mutant

below threshold16.50721.00951No
